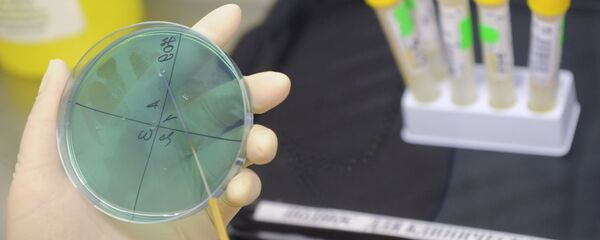

RĪGA, 20. marts — Sputnik. Biotehnoloģiju uzņēmums Rigvir uz laiku pārtraucis farmaceitiskā preparāta Rigvir izplatīšanu Latvijā, vēsta BNN.
Grupas uzņēmumu izpilddirektore Kristīne Jučkoviča informēja, ka lēmums pieņemts finansiālu apsvērumu dēļ – preparāta izplatīšana Latvijā ir nerentabla.
Ņemot vērā lēmumu darbu pārtrauc arī Ainas Mucenieces Viroterapijas fonda pamatprogramma.
Preparāts Rigvir tika reklamēts kā pirmais vīruss pasaulē, kas tiek izmantots klīniskajā praksē onkoloģisko slimību agresīvāko formu – melanomas un aizkuņģa dziedzera vēža ārstēšanai. Latvijāļ tas iekļauts kompensējamo preparātu sarakstā.
2016. gadā Veselības inspekcija piesprieda sodu Rigvir ražotājiem par negodīgu reklāmu.
2017. gadā profesionālās mediķu organizācijas (tostarp arī Latvijas onkologu asociācija) nosūtīja Veselības ministrijai vēstuli, kurā lūdza svītrot Rigvir no kompensējamo zāļu saraksta un valsts medimamentu reģistra, kā arī izvērtēt oficiālo melanomas ārstēšanas protokolu, kas paredz Rigvir lietošanu, jo preparāta efektivitāte nav pierādīta.
Piedevām šaubas par Rigvir efektivitāti pauda arī biedrība par atklātību Dlelna, kam īpaši nepatika fakts, ka Latvijas galvenā onkoloģe Dace Baltiņa strādā Vitoterapijas centrā.
Saskaņā ar LTV datiem, 2017. gadā Rigvir bija viens no visvairāk pārdotajiem recepšu medikamentiem Latvijā, turklāt tā realizācijas apjomi auga ātrāk nekā citiem populāriem farmaceitiskajiem preparātiem.
Aizvadītajā gadā Rigvir sāka restrukturizāciju attīstībai starptautiskā līmenī.